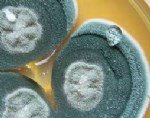

Turunçgil Depo Çürüklüğü Hast. Belirtileri, Nedenleri Ve Mücadelesi
Turunçgil üreticileri için hasat sonrası kayıpların en büyük nedeni olan Depo Çürüklüğü Hastalıkları, doğru yönetim stratejileriyle önlenebilir.
İşte Turunçgil Depo Çürüklüğü Hastalıkları'nın (Yeşil Küf, Mavi Küf ve Ekşi Çürüklük) belirtileri, nedenleri ve etkili mücadele yöntemlerini içeren makale;
🍋 Turunçgil Depo Çürüklüğü Hastalıkları: Hasat Sonrası Kayıpların Önlenmesi İçin Kılavuz
Turunçgil meyveleri, ağaçtan toplandıktan sonra depolama ve nakliye süreçlerinde hızla bozulmaya başlar. Depo Çürüklüğü Hastalıkları, özellikle Yeşil Küf (Penicillium digitatum) ve Mavi Küf (Penicillium italicum) mantarları başta olmak üzere, meyvelerin pazar değerini tamamen yok eden ve üreticilerin kârını düşüren en önemli sorunlardır.
Mücadele, hasat öncesinde başlar ve meyvenin tüketiciye ulaşana kadar süren tüm aşamalarını kapsar.
1. Depo Çürüklüğü Hastalıklarının Etmenleri ve Nedenleri
Turunçgil depo çürüklükleri, genellikle yaralanma bölgelerinden meyveye giren farklı mantar ve bakteri türlerinden kaynaklanır.
A. Başlıca Etmenler:
| Hastalık Adı | Etmeni | Önem Derecesi |
| Yeşil Küf | Penicillium digitatum (Mantar) | En yaygın ve en hızlı yayılan çürüklük. |
| Mavi Küf | Penicillium italicum (Mantar) | Yeşil küfe göre daha yavaş gelişir. |
| Ekşi Çürüklük | Geotrichum citri-aurantii (Mantar) | Tedavisi zor, karakteristik ekşi kokulu çürüklük. |
B. Enfeksiyon Kaynağı ve Giriş Yolları:
-
Yayılım Kaynağı: Mantar sporları, ambalaj malzemelerinde, depo zemininde, çürümüş meyve artıklarında ve paketleme tesislerinin havada kolayca bulunur.
-
Giriş Kapısı (Neden): Depo çürüklüğüne neden olan mantarların tamamı, sağlıklı kabuktan içeri giremez. Enfeksiyonun temel nedeni, hasat ve taşıma sırasında oluşan mekanik yaralanmalardır (çizikler, ezikler, kopan sap yerleri).
-
Koşullar: Yüksek nem ve ılık depolama sıcaklıkları, mantar gelişimini hızlandırır.
2. Depo Çürüklüğü Hastalığı Belirtileri
Çürüklük tipleri, özellikle oluşan küfün rengine ve yayılım şekline göre ayrılır.
A. Yeşil Küf (Penicillium digitatum) Belirtileri:
-
Hızlı Gelişim: Meyvenin en hızlı çürümesine neden olan türdür.
-
Yumuşak Doku: Meyve yüzeyinde sulu, yumuşak bir alan oluşur.
-
Yeşil Toz: Kısa sürede bu yumuşak alan üzerinde beyaz miseller gelişir, ardından merkezden dışa doğru zeytin yeşili renkte yoğun bir spor tabakası (küf) oluşur.
-
Yayılım: Yeşil küf, diğer meyvelere doğrudan temas etmedikçe yayılmaz.
B. Mavi Küf (Penicillium italicum) Belirtileri:
-
Yayılım Hızı: Yeşil küfe göre daha yavaş yayılır.
-
Mavi Toz: Gelişen küfün rengi, adından anlaşıldığı gibi parlak mavi-morumsu bir renktedir.
-
Bulaşma Yeteneği: Mavi küf, sağlıklı meyve kabuklarını dahi enfekte edebilecek kadar agresif değildir, ancak temasta bulunan hasarlı meyveler arasında kolayca yayılır.
C. Ekşi Çürüklük (Geotrichum citri-aurantii) Belirtileri:
-
Sululuk ve Koku: Meyve çok sulu hale gelir ve özellikle çürüyen alandan karakteristik ekşi ve kötü bir koku yayılır.
-
Çözülme: Meyve dokusu yumuşar ve adeta dağılır (erir).
-
Misel Yokluğu: Diğer küf türlerinin aksine, meyve yüzeyinde belirgin küf miseli veya spor yapısı (toz) oluşturmaz, bu da tanısını zorlaştırabilir.
3. Depo Çürüklüğü Hastalığı ile Mücadele Yöntemleri
Mücadele, enfeksiyonu önlemek için üç aşamalı bir strateji gerektirir: Hasat Öncesi, Hasat Sırası ve Hasat Sonrası.
A. Hasat Öncesi ve Sırasında (Mekanik Zararı Önleme):
-
Doğru Hasat: Meyveler, hava kuru ve serin olduğunda toplanmalıdır. Yağmurdan hemen sonra hasat yapılmamalıdır.
-
Mekanik Zararı Önleme: Meyveler ağaçtan koparılırken mutlaka sapı ile birlikte ve makas kullanılarak kesilmelidir. Tırnakla koparma veya sert düşürme kesinlikle yasaktır.
-
Hijyen: Kasalar, taşıma araçları ve tüm ekipman temiz ve dezenfekte edilmiş olmalıdır.
-
Hızlı Soğutma: Hasat edilen meyveler mümkün olan en kısa sürede paketleme tesisine ulaştırılmalı ve hızlıca soğutularak mantar gelişim hızı düşürülmelidir.
B. Hasat Sonrası ve Depolama (Kimyasal ve Fiziksel Kontrol):
-
Temizlik ve Dezenfeksiyon: Paketleme tesisi, depo zeminleri ve ambalaj malzemeleri düzenli olarak fungisitli ve dezenfektanlı suyla temizlenmelidir.
-
Fungisit Uygulaması: Meyveler, yıkama veya mumlama (waxing) aşamasında, ruhsatlı ve uygun dozda depo çürüklüğüne karşı fungisit içeren suyla muamele edilmelidir. Bu, yaralanma bölgelerinden mantar girişini engeller.
-
Mumlamanın Önemi: Mum (wax) uygulaması, meyvedeki yaraları kısmen kapatarak sporların girişini engeller ve aynı zamanda nem kaybını yavaşlatır.
-
Uygun Depolama: Meyveler, çürüklük gelişimini yavaşlatacak uygun sıcaklık ve nem koşullarında (Genellikle 4-10C arasında, türe göre değişir) depolanmalıdır.
Özetle, Turunçgil Depo Çürüklükleriyle mücadelede başarı, yaralanmaları en aza indiren nazik hasat teknikleri ve depolama öncesi hijyen ve kimyasal koruma yöntemlerinin titizlikle uygulanmasına bağlıdır.